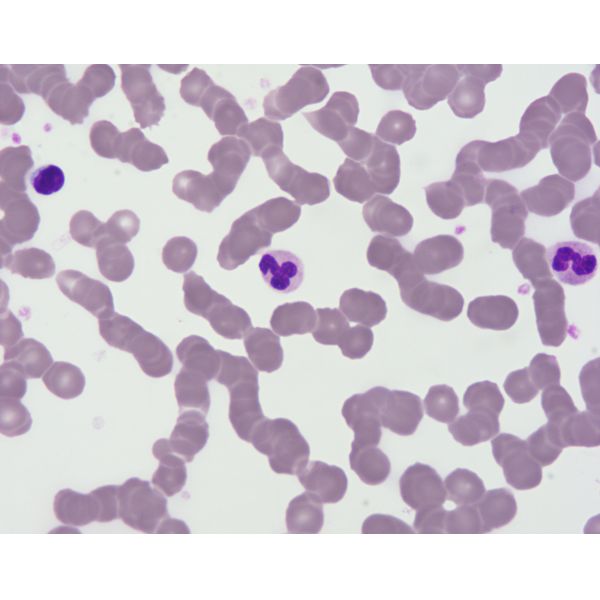

| Sign In | Join Free | My wpc-board.com |
|
- Home
- Products
- About Us
- Quality Control
- Contact Us
- Get Quotations
| Sign In | Join Free | My wpc-board.com |
|
Brand Name : Baso
Certification : IVDR Class A; ISO 13485:2016
MOQ : 1 Box
Price : Negotiated
Payment Terms : T/T
Delivery Time : To be confirmed
Packaging Details : Paper box
Supply Ability : To be confirmed
What is Giemsa Stain (For Blood cells / Plasmodium)?
For blood cell, Plasmodium staining. Giemsa stain contains methylene blue and eosin, the former is alkaline, the latter is acidic, they have a different affinity with the various substances in the cell, so that it can show different colors to identify.
Staining Results

Order Information
|
Product Name
| Ref # | Specification |
|
Giemsa Stain (For Blood cells / Plasmodium)
| BA4122 | 100mL + 4×250mL |
|
Giemsa Stain (For Blood cells / Plasmodium) - A Solution
| BA4122L | 500mL |
|
Giemsa Stain (For Blood cells / Plasmodium) - B Solution
| BA4220 | 1000mL |
|
|
IVDR Class A Giemsa Stain Reagents For Blood Cells / Plasmodium Images |